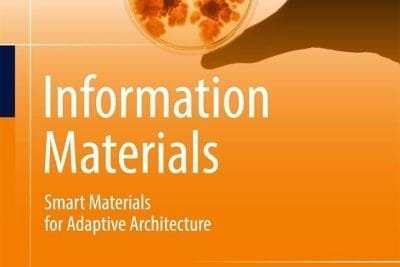

Materiales Innovadores en Arquitectura, de Anna Sandak y Jakub Sandak
Materiales Innovadores en Arquitectura, de Anna Sandak y Jakub Sandak
La revolución de los Materiales Inteligentes, de Alfred J. Crosby
El Mundo Material de la Arquitectura Moderna

La Arquitectura de Materiales Naturales, de David Pearson
La Arquitectura de Materiales Naturales: un fascinante viaje a través del mundo de la arquitectura a través de este libro de David Pearson
Leer más
Materiales para Arquitectos y Diseñadores, de Arthur Lyons
Materiales para Arquitectos y Diseñadores de Lyons, una guía completa sobre los materiales de construcción.
Leer más
Materiales inteligentes en arquitectura, arquitectura de interiores y diseño, de Axel Ritter
Materiales inteligentes: conoce el emocionante mundo de los materiales inteligentes en Arquitectura, de la mano de Axel Ritter
Leer más
Arquitectura de Hormigón , de Catherine Croft
Concrete Architecture, de Catherine Croft explora la historia y las posibilidades del concreto como material de construcción.
Leer más
Materiales Innovadores para la Arquitectura y el Diseño, de Manuel Kretzer
Materiales Innovadores para la Arquitectura y el Diseño, de Manuel Kretzer, explora los materiales innovadores para la arquitectura y el diseño.
Leer más
Arquitectura en la Era Digital, de Branko Kolarevic
Arquitectura en la Era Digital, de Branko Kolarevic explora la influencia de la tecnología digital en la arquitectura.
Leer más
Entornos Responsivos, de Lucy Bullivant
Entornos Responsivos: Un Viaje a la Arquitectura del Futuro ¡Hola a todos! ¿Alguna vez se han preguntado cómo la arquitectura puede adaptarse a nuestras…
Leer más